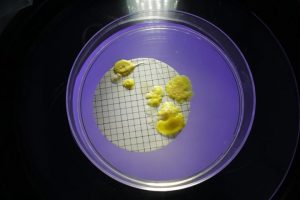

Um den Bioburden eines Produktes zu bestimmen, werden Mikroorganismen mittels einer mechanischen Behandlung mit einer Spüllösung (Eluiermittel) vom Medizinprodukt abgelöst, auf feste Kulturmedien übertragen und unter speziellen validierten Bedingungen inkubiert. Die quantitative Bestimmung der Keimbelastung wird in KBE (koloniebildende Einheiten) bzw. CFU (Colony Forming Units) angegeben und gibt die makroskopisch auszählbare Anzahl an gewachsenen Kolonien auf dem Kulturmedium an (siehe Bild).
Abbildung 1: Beispiele für Bioburden. Bakterielle Kontamination eines Produkts nach 5 Tagen Inkubation des Nährmediums. ®senetics healthcare group

Abbildung 2: Beispiele für Bioburden. Nahaufnahme gewachsener Pilzkolonien nach 7 Tagen Inkubation.®senetics healthcare group
Validierung der Analysemethoden
Da Material, Form und Verarbeitung eines Medizinproduktes Einfluss auf die Rückgewinnbarkeit von Mikroorganismen haben, ist es normativ vorgegeben bei einer Ersttestung auf den Bioburden das Maß der Wiederfindung zu validieren. Hierfür wird ein steriles Produkt mit einer bekannten Konzentration eines Prüforganismus gezielt kontaminiert. Anschließend wird bestimmt, wieviel dieser Kontamination bei der Prüfung zurückgewonnen werden kann. Daraus lässt sich ein Korrekturfaktor berechnen, der dabei hilft, den realen Bioburden eines Produktes zu bestimmen. Die Norm DIN EN ISO 11737-1 definiert Ausnahmen, wann von einer Validierung der Methode abgesehen werden darf. Das Biolabs berät Sie gerne bezüglich der Anforderungen an Ihr Medizinprodukt.
Mikrobielle Analytik
Bei einer bestehenden mikrobiellen Kontamination eines Medizinproduktes ist es wichtig, die Quelle dieser Kontamination zu bestimmen. Ein wichtiges Werkzeug hierfür ist die Bestimmung der Spezies der gewachsenen Mikroorganismen. Hierfür bieten wir Ihnen die mikrobielle Charakterisierung der KBE an, um die Abläufe bei der Herstellung Ihres Medizinproduktes nachhaltig zu optimieren.
Weiterführende Informationen zu anderen Testungen Ihres Medizinproduktes finden Sie unter den folgenden Links: